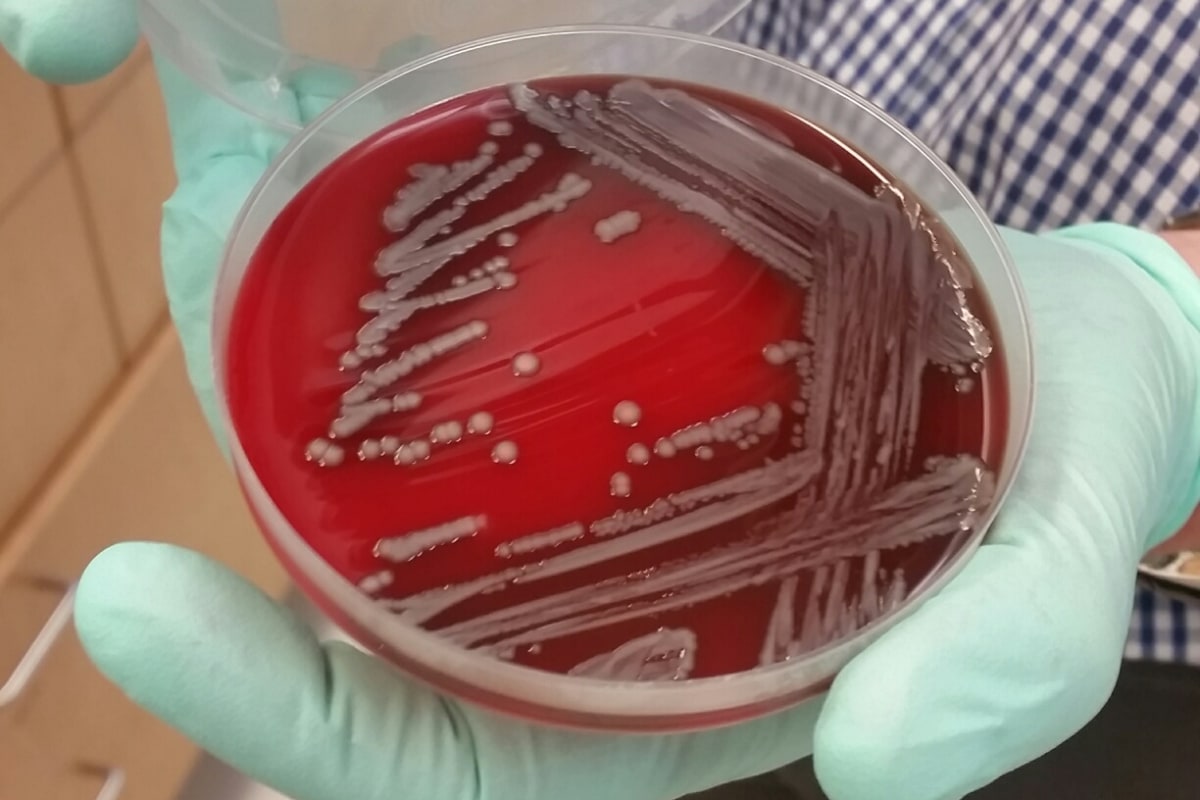

иелла лечится
Клебсиелла лечится 114 фотографий
Американский рэмбо
Что значит фпв дрон это простыми словами
Eminem lucky you
Распределительное свойство умножения 6 класс самостоятельная работа
Cut between
Самые крутые лодки
Gimbal motors
Тарифы банка втб для физических лиц
Синусовая аритмия что это опасно
Королева чаш в сочетании